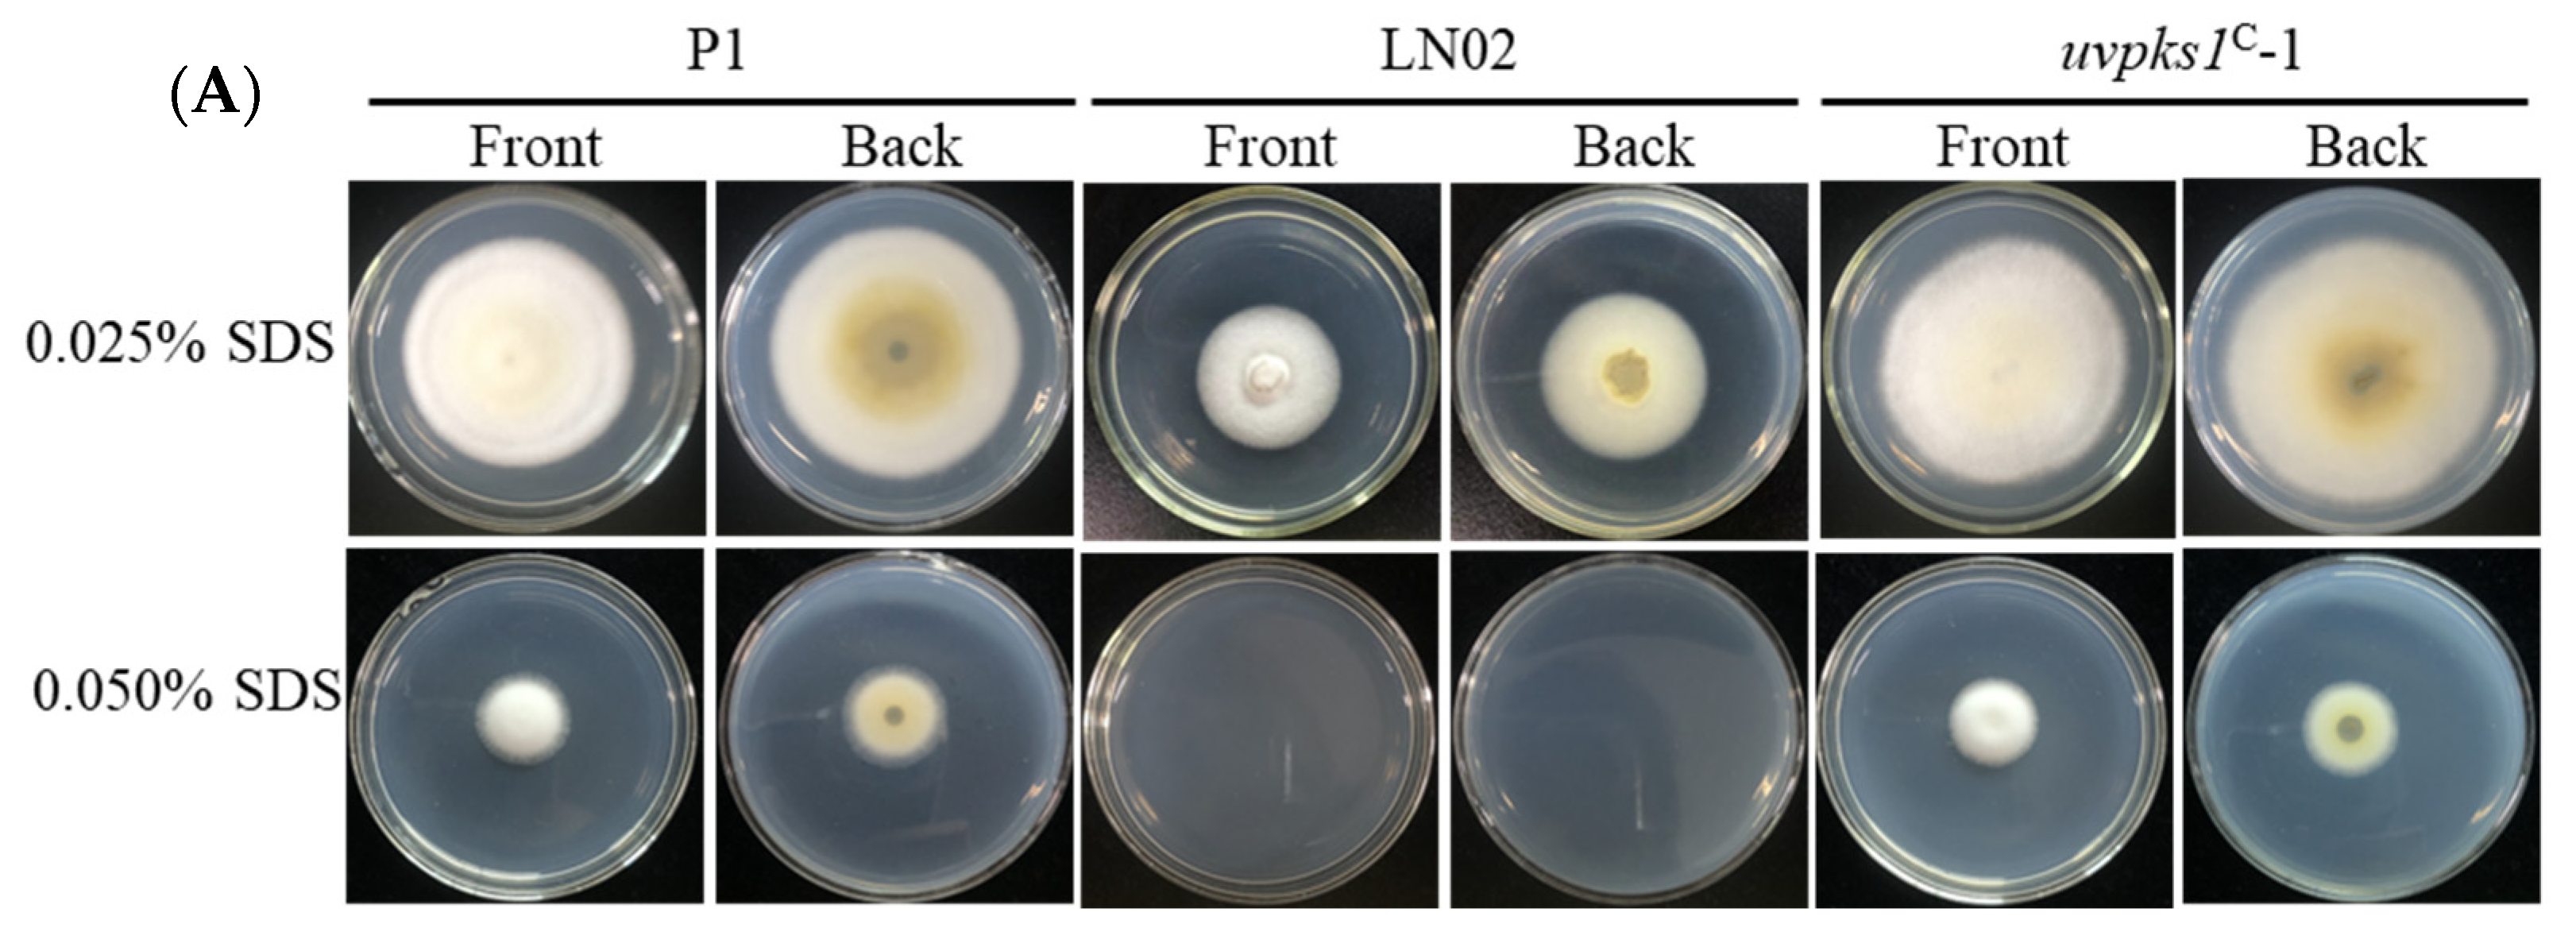
Jof 10 00031 g007a

Activation of Ustilaginoidin Biosynthesis Gene uvpks1 in Villosiclava virens Albino Strain LN02 Influences Development, Stress Responses, and Inhibition of Rice Seed Germination
Abstract
:1. Introduction
2. Materials and Methods
2.1. Fungal Strains
2.2. Assessment of Sporulation and Conidia Germination
2.3. Transient Expression Assay
2.4. Effects of Environmental Stresses on Mycelial Growth of Fungal Strains
2.5. Effects of Fungal Extracts on Germination of Rice Seeds
2.6. Statistical Analysis
3. Results
3.1. Activation of uvpks1 Increased Sporulation and Conidia Germination
3.2. Activation of uvpks1 Influenced Fungal Resistance to Environmental Stresses
3.2.1. Activation of uvpks1 Increased Mycelial Growth at Relatively low Temperature
3.2.2. Activation of uvpks1 Increased Fungal Growth at pH Values from 5.5 to 7.5
3.2.3. Activation of uvpks1 Increased Fungal Resistance to NaCl-Induced Osmotic Stress
3.2.4. Activation of uvpks1 Increased Fungal Resistances to Congo Red-Induced Cell Wall Stress
3.2.5. Activation of uvpks1 Increased Resistance to SDS-Induced Cell Membrane Stress
3.2.6. Activation of uvpks1 Increased Fungal Resistance to H2O2-Induced Oxidative Stress
3.3. Activation of uvpks1 Increased Inhibition by the Fungal Extracts of Germination of Rice Seeds
4. Discussion
5. Conclusions
Supplementary Materials
Author Contributions
Funding
Institutional Review Board Statement
Informed Consent Statement
Data Availability Statement
Acknowledgments
Conflicts of Interest
References
- Abbas, H.K.; Shier, W.T.; Cartwright, R.D.; Sciumbato, G.L. Ustilaginoidea virens infection of rice in Arkansas: Toxicity of false smut galls, their extracts and the ustiloxin fraction. Am. J. Plant Sci. 2014, 5, 3166–3176. [Google Scholar] [CrossRef]
- Sun, W.; Fan, J.; Fang, A.; Li, Y.; Tariqjaveed, M.; Li, D.; Hu, D.; Wang, W.-M. Ustilaginoidea virens: Insights into an emerging rice pathogen. Annu. Rev. Phytopathol. 2020, 58, 363–385. [Google Scholar] [CrossRef] [PubMed]
- Lore, J.S.; Jain, J.; Kumar, S.; Kamboj, I.; Khanna, R.; Dhillon, B.S.; Zaidi, N.W.; Singh, U.S. Prevention of false smut (Ustilaginoidea virens) on rice hybrids and pure-line cultivars by manipulating planting date. J. Phytopathol. 2021, 169, 597–606. [Google Scholar] [CrossRef]
- Bashyal, B.M.; Yadav, G.K.; Parmar, P.; Sunani, S.K.; Aggarwal, S.; Krishnan, S.G.; Kumar, A.; Zaidi, N.W.; Aggarwal, R. High-quality genome resource of Ustilaginoidea virens (UV2_4G), causal agent of an emerging false smut disease in rice. Plant Dis. 2023, 107, 896–898. [Google Scholar] [CrossRef] [PubMed]
- Honkura, R.; Miura, Y.; Tsuji, H. Occurrence of white false smut of rice plant that shows the infection route in hill. Ann. Rep. Plant Prot. North Jpn. 1991, 42, 24–26. [Google Scholar]
- Wang, S.; Li, M.; Dong, H.; Liu, X.-Z.; Bai, Y.-J.; Yang, H. Sporulation, inoculation methods and pathogenicity of Ustilaginoidea albicans, the cause of white rice false smut in China. J. Phytopathol. 2008, 156, 755–757. [Google Scholar] [CrossRef]
- Jin, J.; Chen, H.-M.; Xu, W.; Yang, B.-H.; Hu, D. The isolation and biological features of two albinotic isolates of Ustilaginoidea virens. Mycosystema 2012, 31, 567–573. [Google Scholar]
- Jecmen, A.C.; TeBeest, D.O. First report of the occurrence of a white smut infecting rice in Arkansas. J. Phytopathol. 2015, 163, 138–143. [Google Scholar] [CrossRef]
- Fadiji, A.E.; Babalola, O.O. Elucidating mechanisms of endophytes used in plant protection and other bioactivities with multifunctional prospects. Front. Bioeng. Biotechnol. 2020, 8, 467. [Google Scholar] [CrossRef]
- Pusztahelyi, T.; Holb, I.J.; Pocsi, I. Secondary metabolites in fungus-plant interactions. Front. Plant Sci. 2015, 6, 573. [Google Scholar] [CrossRef]
- Xue, M.; Zhao, S.; Gu, G.; Xu, D.; Zhang, X.; Hou, X.; Miao, J.; Dong, H.; Hu, D.; Lai, D.; et al. A genome-wide comparison of rice false smut fungus Villosiclava virens albino strain LN02 reveals the genetic diversity of secondary metabolites and the cause of albinism. Int. J. Mol. Sci. 2023, 24, 15196. [Google Scholar] [CrossRef] [PubMed]
- Lv, B.; Zheng, L.; Liu, H.; Tang, J.; Hsiang, T.; Huang, J. Use of random T-DNA mutagenesis in identification of gene UvPRO1, a regulator of conidiation, stress response, and virulence in Ustilaginoidea virens. Front. Microbiol. 2016, 7, 2086. [Google Scholar] [CrossRef] [PubMed]
- Wang, Y.; Wang, F.; Xie, S.; Liu, Y.; Qu, J.; Huang, J.; Yin, W.; Luo, C. Development of rice conidiation media for Ustilaginoidea virens. PLoS ONE 2019, 14, e0217667. [Google Scholar] [CrossRef] [PubMed]
- Zhang, X.; Xu, D.; Hou, X.; Wei, P.; Fu, J.; Zhao, Z.; Jing, M.; Lai, D.; Yin, W.; Zhou, L. UvSorA and UvSorB involved in sorbicillinoid biosynthesis contribute to fungal development, stress response and phytotoxicity in Ustilaginoidea virens. Int. J. Mol. Sci. 2022, 23, 11056. [Google Scholar] [CrossRef] [PubMed]
- Chen, S.; Tao, L.; Zeng, L.; Vega-Sanchez, M.E.; Umemura, K.; Wang, G.-L. A highly efficient transient protoplast system for analyzing defence gene expression and protein-protein interactions in rice. Mol. Plant Pathol. 2006, 7, 417–427. [Google Scholar] [CrossRef]
- Zong, Y.; Li, B.; Tian, S. Effects of carbon, nitrogen and ambient pH on patulin production and related gene expression in Penicillium expansum. Int. J. Food Microbiol. 2015, 206, 102–108. [Google Scholar] [CrossRef]
- Lu, S.; Sun, W.; Meng, J.; Wang, A.; Wang, X.; Tian, J.; Fu, X.; Dai, J.; Liu, Y.; Lai, D.; et al. Bioactive bis-naphtho-γ-pyrones from rice false smut pathogen Ustilaginoidea virens. J. Agric. Food Chem. 2015, 63, 3501–3508. [Google Scholar] [CrossRef] [PubMed]
- Macheleidt, J.; Mattern, D.J.; Fischer, J.; Netzker, T.; Weber, J.; Schroeckh, V.; Valiante, V.; Brakhage, A.A. Regulation and role of fungal secondary metabolites. Annu. Rev. Genet. 2016, 50, 371–392. [Google Scholar] [CrossRef]
- Chen, Y.; Liu, Y.; Zhang, J.; Li, L.; Wang, S.; Gao, M. Lack of the histone methyltransferase gene Ash2 results in the loss of citrinin production in Monascus purpureus. J. Food Prot. 2020, 83, 702–709. [Google Scholar] [CrossRef]
- Jia, M.; Chen, L.; Xin, H.-L.; Zheng, C.-J.; Rahman, K.; Han, T.; Qin, L.-P. A friendly relationship between endophytic fungi and medicinal plants: A systematic review. Front. Microbiol. 2016, 7, 906. [Google Scholar] [CrossRef]
- Van der Does, H.C.; Rep, M. Adaptation to the host environment by plant-pathogenic fungi. Annu. Rev. Phytopathol. 2017, 55, 427–450. [Google Scholar] [CrossRef] [PubMed]
- Verma, A.; Shameem, N.; Jatav, H.S.; Sathyanarayana, E.; Parray, J.A.; Poczai, P.; Sayyed, R.Z. Fungal endophytes to combat biotic and abiotic stresses for climate-smart and sustainable agriculture. Front. Plant Sci. 2022, 13, 953836. [Google Scholar] [CrossRef] [PubMed]
- Anand, U.; Pal, T.; Yadav, N.; Singh, V.K.; Tripathi, V.; Choudhary, K.K.; Shukla, A.K.; Sunita, K.; Kumar, A.; Bontempi, E.; et al. Current scenario and future prospects of endophytic microbes: Promising candidates for abiotic and biotic stress management for agricultural and environmental sustainability. Microb. Ecol. 2023, 86, 1455–1486. [Google Scholar] [CrossRef] [PubMed]
- Hassan, N.; Rafiq, M.; Hayat, M.; Shah, A.A.; Hasan, F. Psychrophilic and psychrotrophic fungi: A comprehensive review. Rev. Environ. Sci. Bio-Technol. 2016, 15, 147–172. [Google Scholar] [CrossRef]
- Chen, Y.; Li, B.; Xu, X.; Zhang, Z.; Tian, S. The pH-responsive PacC transcription factor plays pivotal roles in virulence and patulin biosynthesis in Penicillium expansum. Environ. Microbiol. 2018, 20, 4063–4078. [Google Scholar] [CrossRef] [PubMed]
- Gardiner, D.M.; Osborne, S.; Kazan, K.; Manners, J.M. Low pH regulates the production of deoxynivalenol by Fusarium graminearum. Microbiology 2009, 155, 3149–3156. [Google Scholar] [CrossRef] [PubMed]
- Overy, D.; Correa, H.; Roullier, C.; Chi, W.-C.; Pang, K.-L.; Rateb, M.; Ebel, R.; Shang, Z.; Capon, R.; Bills, G.; et al. Does osmotic stress affect natural product expression in fungi? Mar. Drugs 2017, 15, 254. [Google Scholar] [CrossRef]
- Udompaisarn, S.; Toopaang, W.; Sae-Ueng, U.; Srisuksam, C.; Wichienchote, N.; Wasuwan, R.; Nahar, N.A.S.; Tanticharoen, M.; Amnuaykanjanasin, A. The polyketide synthase PKS15 has a crucial role in cell wall formation in Beauveria bassiana. Sci. Rep. 2020, 10, 12630. [Google Scholar] [CrossRef]
- Deng, S.; Yao, C.; Zhang, X.; Jia, Z.; Shan, C.; Luo, X.; Lin, L. Involvement of UDP-glucose pyrophosphorylase from Verticillium dahliae in cell morphogenesis, stress responses, and host infection. Fungal Biol. 2020, 124, 648–660. [Google Scholar] [CrossRef]
- Zhang, C.; Wang, W.; Lu, R.; Jin, S.; Chen, Y.; Fan, M.; Huang, B.; Li, Z.; Hu, F. Metabolic responses of Beauveria bassiana to hydrogen peroxide-induced oxidative stress using an LC-MS-based metabolomics approach. J. Invertebr. Pathol. 2016, 137, 1–9. [Google Scholar] [CrossRef]
- Pontes, J.G.M.; Fernandes, L.S.; Santos, R.V.; Tasic, L.; Fill, T.P. Virulence factors in the phytopathogen-host interactions: An overview. J. Agric. Food Chem. 2020, 68, 7555–7570. [Google Scholar] [CrossRef] [PubMed]
- Evidente, A.; Cimmino, A.; Masi, M. Phytotoxins produced by pathogenic fungi of agrarian plants. Phytochem. Rev. 2019, 18, 843–870. [Google Scholar] [CrossRef]
- Chakraborty, A.; Ray, P. Mycoherbicides for the noxious meddlesome: Can Colletotrichum be a budding candidate? Front. Microbiol. 2021, 12, 754048. [Google Scholar] [CrossRef] [PubMed]
- Gan, D.; Liu, J.; Yang, Y.; Wang, C.; Zhu, L.; Li, C.; Cai, L.; Ding, Z. Phytotoxic meroterpenoids with herbicidal activities from the phytopathogenic fungus Pseudopestalotiopsis theae. Phytochemistry 2023, 206, 113522. [Google Scholar] [CrossRef] [PubMed]
- Zeilinger, S.; Gupta, V.K.; Dahms, T.E.S.; Silva, R.N.; Singh, H.B.; Upadhyay, R.S.; Gomes, E.V.; Tsui, C.K.-M.; Chandra, H.S. Friends or foes? Emerging insights from fungal interactions with plants. FEMS Microbiol. Rev. 2016, 40, 182–207. [Google Scholar] [CrossRef] [PubMed]
- Keller, N.P. Translating biosynthetic gene clusters into fungal armor and weaponry. Nat. Chem. Biol. 2015, 11, 671–677. [Google Scholar] [CrossRef] [PubMed]
- Keller, N.P. Fungal secondary metabolism: Regulation, function and drug discovery. Nat. Rev. Microbiol. 2019, 17, 167–180. [Google Scholar] [CrossRef]
- Elhamouly, N.A.; Hewedy, O.A.; Zaitoon, A.; Miraples, A.; Elshorbagy, O.T.; Hussien, S.; El-Tahan, A.; Peng, D. The hidden power of secondary metabolites in plant-fungi interactions and sustainable phytoremediation. Front. Plant Sci. 2022, 13, 1044896. [Google Scholar] [CrossRef]
- Hashem, A.H.; Attia, M.S.; Kandil, E.K.; Fawzi, M.M.; Abdelrahman, A.S.; Khader, M.S.; Khodaira, M.A.; Eman, A.E.; Goma, M.A.; Abdelaziz, A.M. Bioactive compounds and biomedical applications of endophytic fungi: A recent review. Microb. Cell Fact. 2023, 22, 107. [Google Scholar] [CrossRef]
- Jha, P.; Kaur, T.; Chhabra, I.; Panja, A.; Paul, S.; Kumar, V.; Malik, T. Endophytic fungi: Hidden treasure chest of antimicrobial metabolites interrelationship of endophytes and metabolites. Front. Microbiol. 2023, 14, 1227830. [Google Scholar] [CrossRef]
- Koiso, Y.; Natori, M.; Iwasaki, S.; Sato, S.; Sonoda, R.; Fujita, Y.; Yaegashi, H.; Sato, Z. Ustiloxin: A phytotoxin and a mycotoxin from false smut balls on rice panicles. Tetrahedron Lett. 1992, 33, 4157–4160. [Google Scholar] [CrossRef]
- Koiso, Y.; Li, Y.; Iwasaki, S.; Hanaoka, K.; Kobayashi, T.; Sonoda, R.; Fujita, Y.; Yaegashi, H.; Sato, Z. Ustiloxins, antimitotic cyclic peptides from false smut balls on rice panicles caused by Ustilaginoidea virens. J. Antibiot. 1994, 47, 765–773. [Google Scholar] [CrossRef] [PubMed]
- Wang, X.; Wang, J.; Lai, D.; Wang, W.; Dai, J.; Zhou, L.; Liu, Y. Ustiloxin G, a new cyclopeptide mycotoxin from rice false smut balls. Toxins 2017, 9, 54. [Google Scholar] [CrossRef] [PubMed]
- Koyama, K.; Natori, S. Further characterization of seven bis (naphtho-γ-pyrone) congeners of ustilaginoidins, coloring matters of Claviceps virens (Ustilaginoidea virens). Chem. Pharm. Bull. 1988, 36, 146–152. [Google Scholar] [CrossRef]
- Koyama, K.; Ominato, K.; Natori, S.; Tashiro, T.; Tsuruo, T. Cytotoxicity and antitumor activities of fungal bis(naphtha-γ-pyrone) derivatives. J. Pharmacobio-Dyn. 1988, 11, 630–635. [Google Scholar] [CrossRef]
- Sun, W.; Wang, A.; Xu, D.; Wang, W.; Meng, J.; Dai, J.; Liu, Y.; Lai, D.; Zhou, L. New ustilaginoidins from rice false smut balls caused by Villosiclava virens and their phytotoxic and cytotoxic activities. J. Agric. Food Chem. 2017, 65, 5151–5160. [Google Scholar] [CrossRef] [PubMed]
- Lai, D.; Meng, J.; Zhang, X.; Xu, D.; Dai, J.; Zhou, L. Ustilobisorbicillinol A, a cytotoxic sorbyl-containing aromatic polyketide from Ustilagninoidea virens. Org. Lett. 2019, 21, 1311–1314. [Google Scholar] [CrossRef]
- Meng, J.; Gu, G.; Dang, P.; Zhang, X.; Wang, W.; Dai, J.; Liu, Y.; Lai, D.; Zhou, L. Sorbicillinoids from the fungus Ustilaginoidea virens and their phytotoxic, cytotoxic, and antimicrobial activities. Front. Chem. 2019, 7, 435. [Google Scholar] [CrossRef]
- Tsuchiya, T.; Sekita, S.; Koyama, K.; Natori, S.; Takahashi, A. Effect of chaetochromin A, chaetochromin D, and ustilaginoidin A, bis(naphtho-γ-pyrone) derivatives, on the mouse embryo limb bud and midbrain cells in culture. Cong. Anom. 1987, 27, 245–250. [Google Scholar] [CrossRef]
- Wang, B.; Liu, Y.; Li, Y.; Zou, J.; Li, D.; Zhao, D.; Li, W.; Sun, W. Ustilaginoidin D induces hepatotoxicity and behaviour aberrations in zebrafish larvae. Toxicology 2021, 456, 15286. [Google Scholar] [CrossRef]
- Harned, A.M.; Volp, K.A. The sorbicillinoid family of natural products: Isolation, biosynthesis, and synthetic studies. Nat. Prod. Rep. 2011, 28, 1790–1810. [Google Scholar] [CrossRef] [PubMed]
- Hou, X.; Zhang, X.; Xue, M.; Zhao, Z.; Zhang, H.; Xu, D.; Lai, D.; Zhou, L. Recent advances in sorbicillinoids from fungi and their bioactivities (covering 2016–2021). J. Fungi 2022, 8, 62. [Google Scholar] [CrossRef] [PubMed]
- Zhang, Y.; Xu, Q.; Sun, Q.; Kong, R.; Liu, H.; Yi, X.; Liang, Z.; Letcher, R.J.; Liu, C. Ustiloxin A inhibits proliferation of renal tubular epithelial cells in vitro and induces renal injury in mice by disrupting structure and respiratory function of mitochondria. J. Hazard. Mater. 2023, 448, 130791. [Google Scholar] [CrossRef] [PubMed]
- Fan, J.; Yang, J.; Wang, Y.-Q.; Li, G.-B.; Li, Y.; Huang, F.; Wang, W.-M. Current understanding on Villosiclava virens, a unique flower-infecting fungus causing rice false smut disease. Mol. Plant Pathol. 2016, 17, 1321–1330. [Google Scholar] [CrossRef] [PubMed]
- Meng, J.; Sun, W.; Mao, Z.; Xu, D.; Wang, X.; Lu, S.; Lai, D.; Liu, Y.; Zhou, L.; Zhang, G. Main ustilaginoidins and their distribution in rice false smut balls. Toxins 2015, 7, 4023–4034. [Google Scholar] [CrossRef] [PubMed]
- Barda, O.; Maor, U.; Sadhasivam, S.; Bi, Y.; Zakin, V.; Prusky, D.; Sionov, E. The pH-responsive transcription factor PacC governs pathogenicity and ochratoxin A biosynthesis in Aspergillus carbonarius. Front. Microbiol. 2020, 11, 210. [Google Scholar] [CrossRef]
- Jimdjio, C.K.; Xue, H.; Bi, Y.; Nan, M.; Li, L.; Zhang, R.; Liu, Q.; Pu, L. Effect of ambient pH on growth, pathogenicity, and patulin production of Penicillium expansum. Toxins 2021, 13, 550. [Google Scholar] [CrossRef]
- Li, B.; Chen, Y.; Tian, S. Function of pH-dependent transcription factor PacC in regulating development, pathogenicity, and mycotoxin biosynthesis of phytopathogenic fungi. FEBS J. 2022, 289, 1723–1730. [Google Scholar] [CrossRef]
- Zhou, Y.; Hou, L.; Zhang, Y.; Fan, Y.; Luo, Z.; Jin, D.; Zhou, Q.; Li, Y.; Wang, Y.; Pei, Y. Expression and promoter characterization of BbPacC, a pH response transcription factor gene of the entomopathogenic fungus Beauveria bassiana. Microbiology 2014, 160, 353–361. [Google Scholar] [CrossRef]
- Xiong, M.; Meng, S.; Qiu, J.; Shi, H.; Shen, X.; Kou, Y. Putative phosphatase UvPsr1 is required for mycelial growth, conidiation, stress response and pathogenicity in Ustilaginonidea virens. Rice Sci. 2020, 27, 529–536. [Google Scholar]
- Li, C.; Zhang, Q.; Xia, Y.; Jin, K. MaAreB, a GATA transcription factor, is involved in nitrogen source utilization, stress tolerances and virulence in Metarhizium acridum. J. Fungi 2021, 7, 512. [Google Scholar] [CrossRef] [PubMed]

Disclaimer/Publisher’s Note: The statements, opinions and data contained in all publications are solely those of the individual author(s) and contributor(s) and not of MDPI and/or the editor(s). MDPI and/or the editor(s) disclaim responsibility for any injury to people or property resulting from any ideas, methods, instructions or products referred to in the content. |
© 2023 by the authors. Licensee MDPI, Basel, Switzerland. This article is an open access article distributed under the terms and conditions of the Creative Commons Attribution (CC BY) license (https://creativecommons.org/licenses/by/4.0/).
Share and Cite
Xue, M.; Hou, X.; Gu, G.; Dong, J.; Yang, Y.; Pan, X.; Zhang, X.; Xu, D.; Lai, D.; Zhou, L. Activation of Ustilaginoidin Biosynthesis Gene uvpks1 in Villosiclava virens Albino Strain LN02 Influences Development, Stress Responses, and Inhibition of Rice Seed Germination. J. Fungi 2024, 10, 31. https://doi.org/10.3390/jof10010031
Xue M, Hou X, Gu G, Dong J, Yang Y, Pan X, Zhang X, Xu D, Lai D, Zhou L. Activation of Ustilaginoidin Biosynthesis Gene uvpks1 in Villosiclava virens Albino Strain LN02 Influences Development, Stress Responses, and Inhibition of Rice Seed Germination. Journal of Fungi. 2024; 10(1):31. https://doi.org/10.3390/jof10010031
Chicago/Turabian StyleXue, Mengyao, Xuwen Hou, Gan Gu, Jie Dong, Yonglin Yang, Xiaoqian Pan, Xuan Zhang, Dan Xu, Daowan Lai, and Ligang Zhou. 2024. "Activation of Ustilaginoidin Biosynthesis Gene uvpks1 in Villosiclava virens Albino Strain LN02 Influences Development, Stress Responses, and Inhibition of Rice Seed Germination" Journal of Fungi 10, no. 1: 31. https://doi.org/10.3390/jof10010031
APA StyleXue, M., Hou, X., Gu, G., Dong, J., Yang, Y., Pan, X., Zhang, X., Xu, D., Lai, D., & Zhou, L. (2024). Activation of Ustilaginoidin Biosynthesis Gene uvpks1 in Villosiclava virens Albino Strain LN02 Influences Development, Stress Responses, and Inhibition of Rice Seed Germination. Journal of Fungi, 10(1), 31. https://doi.org/10.3390/jof10010031

